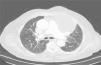

Los linfangiomas quísticos son colecciones focales de tejido linfático benigno de crecimiento lento, originados por una alteración en el desarrollo embrionario o secundario a una obstrucción crónica por cirugía, infección o irradiación1,2. La localización más habitual es en la región de cabeza, cuello (75%) o axilar (20%), aunque también puede presentarse en el tórax (1%)2,3. Pueden permanecer asintomáticos durante largos periodos, si bien por compresión de estructuras adyacentes pueden producir tos crónica, disnea, disfagia e incluso neumotórax y derrame pleural2,4.
Presentamos el caso de una paciente de 80 años, con antecedentes de hipertensión arterial, hipotiroidismo, fibrilación auricular paroxística en tratamiento anticoagulante, neoplasia de mama en el 2006 tratada con cirugía y radioterapia adyuvante, sin recidiva posterior, y tromboembolismo pulmonar en el 2009.
La paciente había ingresado en el servicio de Neumología por episodios repetidos en los últimos 2 años de infección respiratoria con presencia de sibilancias inspiratorias de predominio en hemitórax izquierdo. Se realizó una TAC de tórax, donde se objetivó una lesión quística de 10×9cm que ocasionaba atelectasia parcial del lóbulo superior izquierdo y compresión de estructuras mediastínicas (fig. 1). Se programó una punción de dicha lesión guiada por TAC, cuyo estudio citológico fue compatible con linfangioma quístico.
Tras valoración conjunta con el servicio de Cirugía Torácica, se propuso intervención quirúrgica, realizándose resección del linfangioma mediante toracotomía anterior. En el postoperatorio inmediato presentó insuficiencia respiratoria con estridor y acúmulo de secreciones que obligó a reintubación y traslado a la Unidad de Cuidados Intensivos. Se objetivó además, en la radiografía de control, elevación del hemidiafragma izquierdo indicativa de parálisis frénica posquirúrgica. Tras la extubación se mantuvo soporte con ventilación mecánica no invasiva.
En los días siguientes presentó varios episodios de atelectasias parcial y total del pulmón izquierdo que precisaron fibrobroncoscopias repetidas y colocación de prótesis endobronquial. Finalmente, debido al destete prolongado, se practicó una traqueostomía quirúrgica con retirada posterior de la prótesis endobronquial. Tras la estabilización, se consiguió una disminución progresiva del soporte ventilatorio y requerimientos de oxigenoterapia. Durante su estancia hospitalaria continuó la evolución favorable, siendo posible en los días siguientes la decanulación manteniendo soporte ventilatorio no invasivo nocturno.
Los linfangiomas quísticos intratorácicos son tumoraciones benignas poco frecuentes que suelen aparecer en niños o adultos jóvenes2,4. Su diagnóstico requiere una prueba de imagen (TAC o resonancia magnética), así como confirmación histológica mediante punción guiada por TAC o mediastinoscopia2-4. El tratamiento más efectivo es la cirugía, aunque resecciones incompletas pueden conllevar riesgo de recidiva2,3. Otras posibilidades terapéuticas incluyen aspiración y drenaje de los quistes para descompresiones de urgencia, inyección de sustancias esclerosantes (bleomicina, OK-432) o radioterapia a dosis bajas2.
Consideramos el caso actual de interés dada su baja incidencia en personas mayores y localización intratorácica. Por otra parte, a pesar de que el tratamiento quirúrgico es la opción terapéutica más aceptada debido a su mejor pronóstico y menor riesgo de recidiva, no está exento de morbilidad, como en el caso de nuestra paciente, que presentó múltiples complicaciones tras la cirugía.